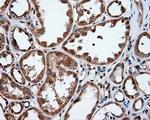
IFIT1 Antibody in Immunohistochemistry (Paraffin) (IHC (P))
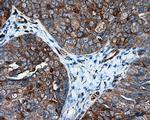
IFIT1 Antibody in Immunohistochemistry (Paraffin) (IHC (P))

Search
OriGene
IFIT1 Monoclonal Antibody (OTI3G8), TrueMAB™
{{$productOrderCtrl.translations['antibody.pdp.commerceCard.promotion.promotions']}}
{{$productOrderCtrl.translations['antibody.pdp.commerceCard.promotion.viewpromo']}}
{{$productOrderCtrl.translations['antibody.pdp.commerceCard.promotion.promocode']}}: {{promo.promoCode}} {{promo.promoTitle}} {{promo.promoDescription}}. {{$productOrderCtrl.translations['antibody.pdp.commerceCard.promotion.learnmore']}}
产品信息
TA500948
种属反应
宿主/亚型
分类
类型
克隆号
抗原
偶联物
形式
浓度
规格
纯化类型
保存液
内含物
保存条件
运输条件
靶标信息
Interferon-induced antiviral RNA-binding protein that specifically binds single-stranded RNA bearing a 5'-triphosphate group (PPP-RNA), thereby acting as a sensor of viral single-stranded RNAs and inhibiting expression of viral messenger RNAs. Single-stranded PPP-RNAs, which lack 2'-O-methylation of the 5' cap and bear a 5'-triphosphate group instead, are specific from viruses, providing a molecular signature to distinguish between self and non-self mRNAs by the host during viral infection. Directly binds PPP-RNA in a non-sequence-specific manner. Viruses evolved several ways to evade this restriction system such as encoding their own 2'-O-methylase for their mRNAs or by stealing host cap containing the 2'-O-methylation (cap snatching mechanism). Exhibits antiviral activity against several viruses including human papilloma and hepatitis C viruses.
仅用于科研。不用于诊断过程。未经明确授权不得转售。
生物信息学
蛋白别名: Antiviral innate immune response effector IFIT1; GARG-16; glucocorticoid-attenuated response gene 16 product; Glucocorticoid-attenuated response gene 16 protein; IFI-56K; IFIT-1; interferon, alpha-inducible protein (MW 56kD); Interferon-induced 56 kDa protein; Interferon-induced protein with tetratricopeptide repeats 1; interferon-induced protein with tetratricopeptide repeats 1-like protein; interferon-inducible mRNA 561; unnamed protein product
基因别名: C56; G10P1; Garg16; IFI-56; IFI-56K; IFI56; IFIT-1; IFIT1; Ifit1b; IFNAI1; ISG56; P56; RNM561
UniProt ID: (Human) P09914, (Mouse) Q64282
Entrez Gene ID: (Human) 3434, (Mouse) 15957, (Rat) 56824